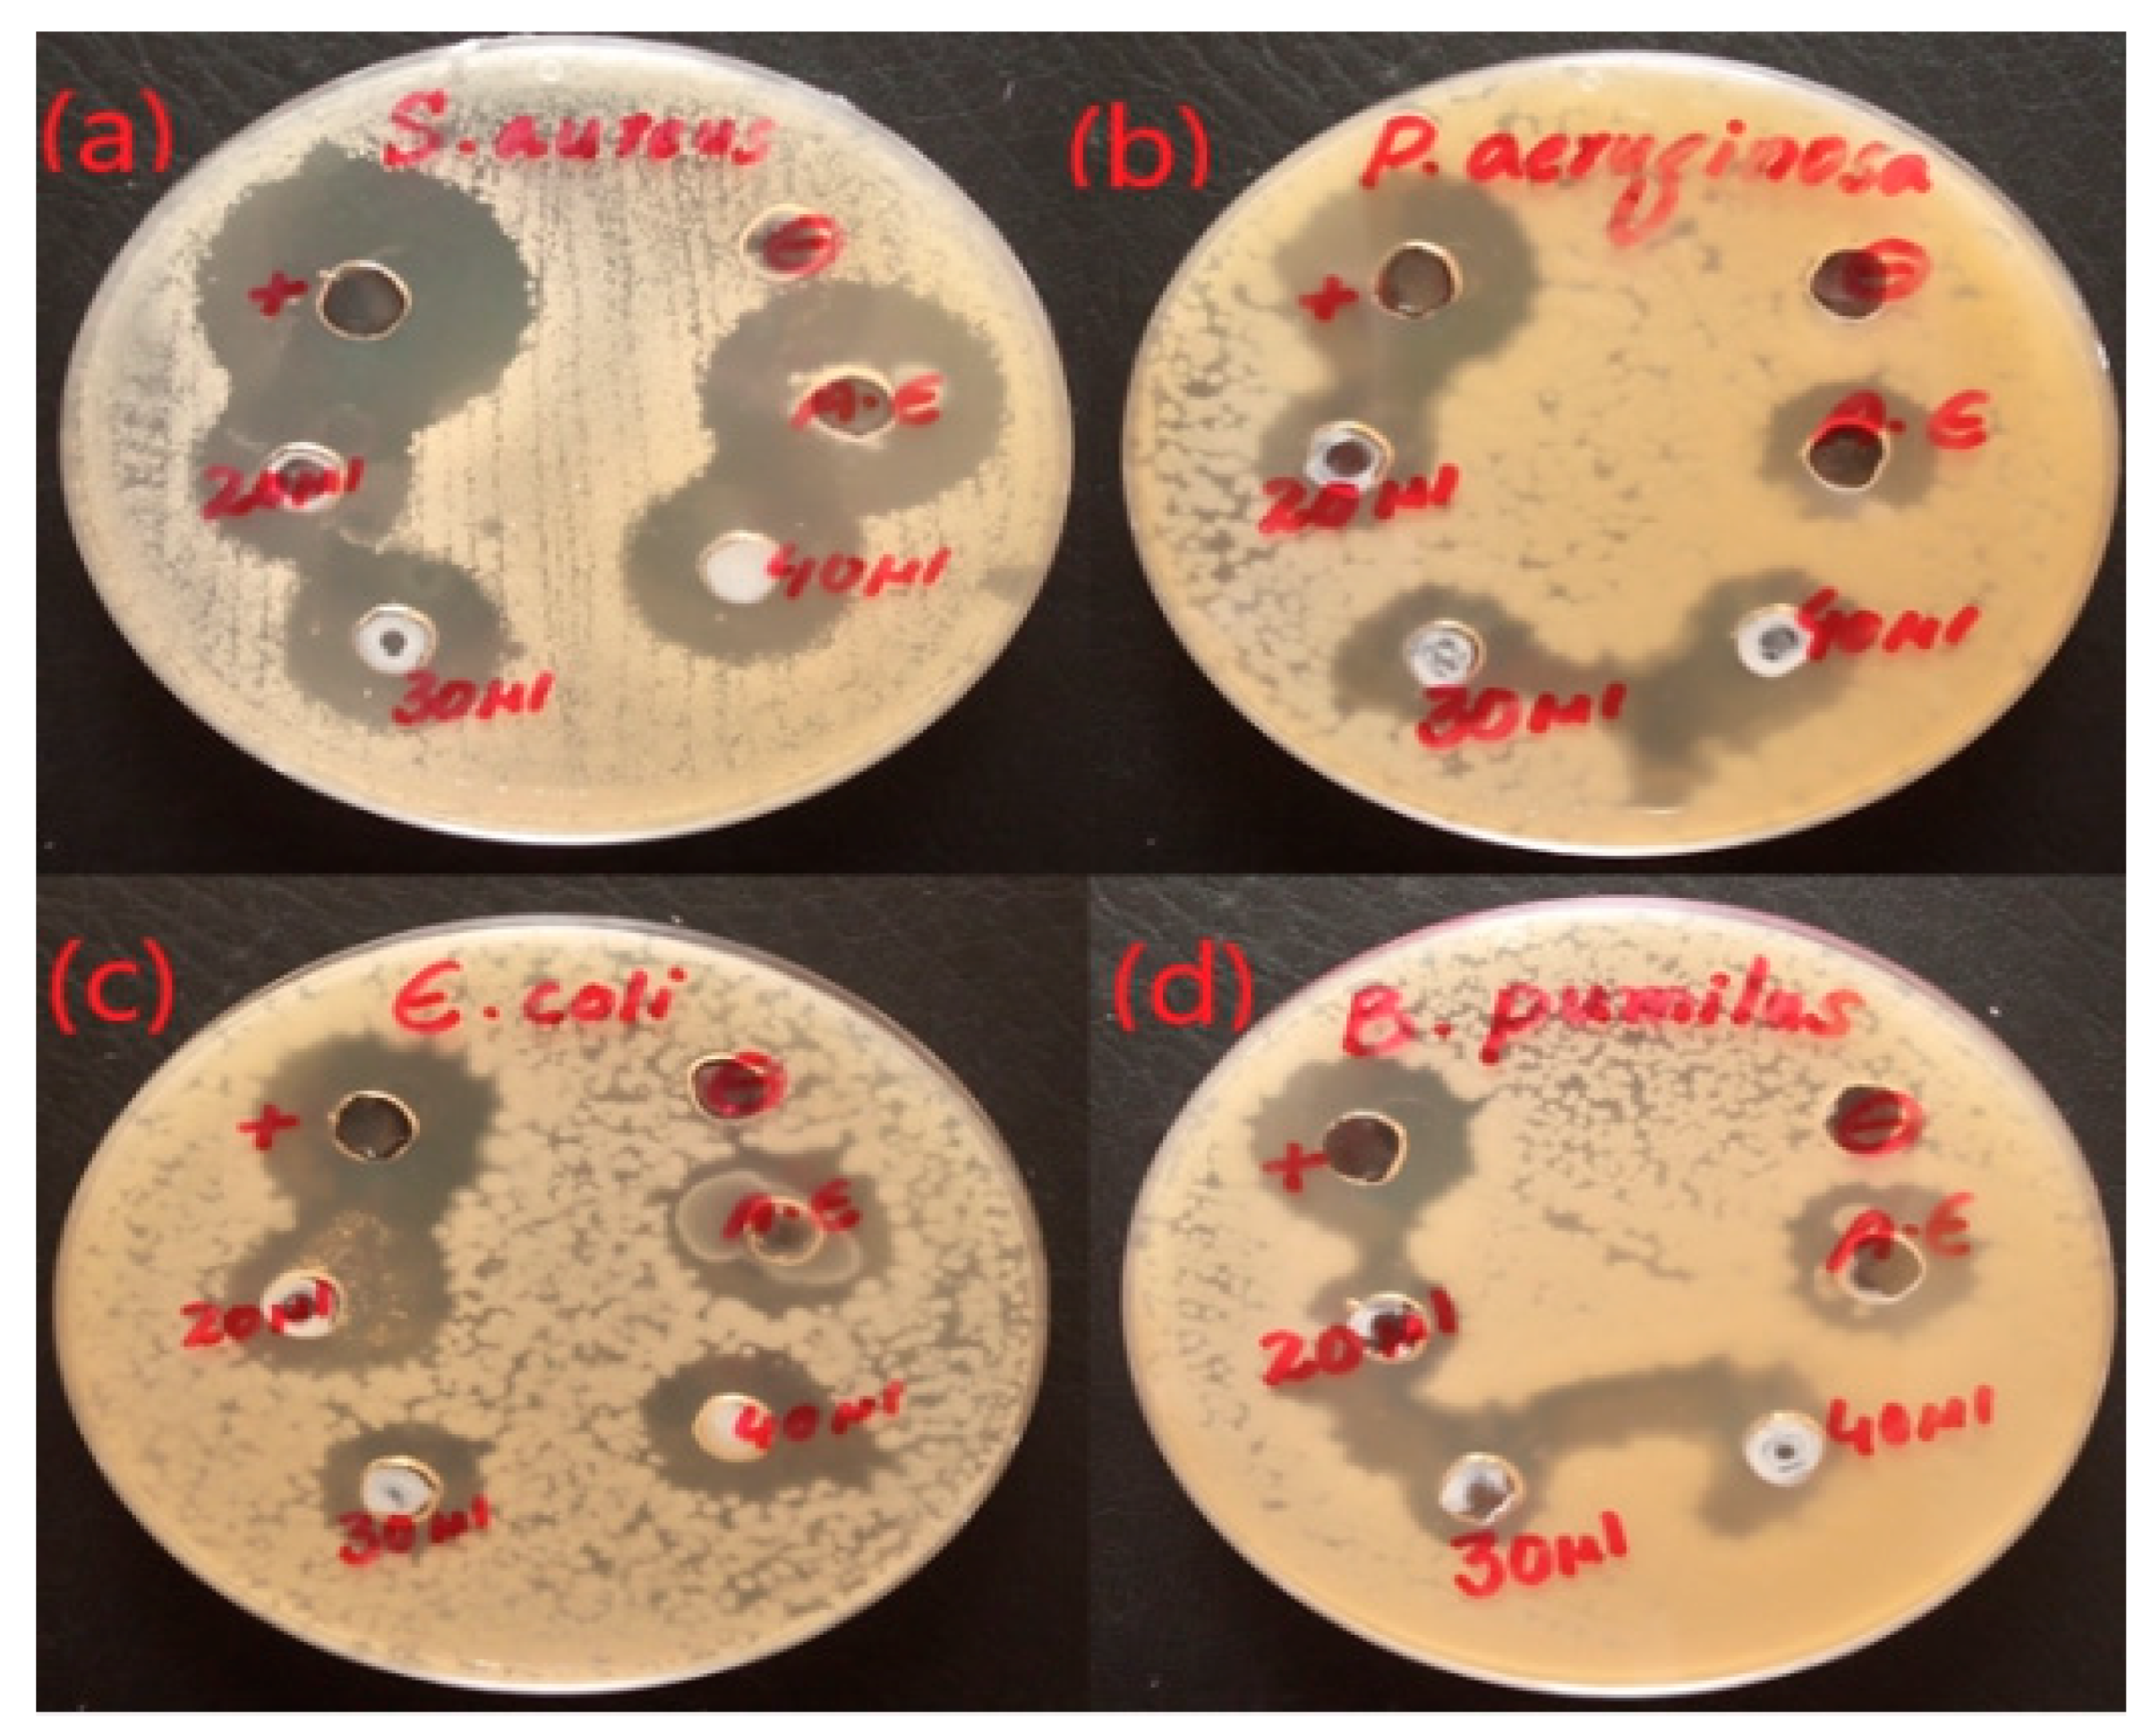
Micromachines 14 00928 g007 Micromachines 14 00928 g007

Green Synthesis of Zinc Oxide (ZnO) Nanoparticles from Green Algae and Their Assessment in Various Biological Applications
Abstract
1. Introduction
2. Results
2.1. UV-Visible Spectroscopy
2.2. Fourier-Transform Infrared Spectroscopy Analysis
2.3. XRD Analysis
2.4. SEM Images of ZnO NPS
2.5. EDX Analysis
2.6. Antibacterial Activity
2.7. Antioxidant Activity
3. Discussion
4. Materials and Methods
4.1. Sampling, Identification, and Extraction of Algae
4.2. Biosynthesis of ZnO Nanoparticles
4.3. Characterization of ZnO NPs
4.4. Antibacterial Activity
4.5. Antioxidant Potential
5. Conclusions
Author Contributions
Funding
Institutional Review Board Statement
Informed Consent Statement
Data Availability Statement
Acknowledgments
Conflicts of Interest
References
- El-Belely, E.F.; Farag, M.M.; Said, H.A.; Amin, A.S.; Azab, E.; Gobouri, A.A.; Fouda, A. Green synthesis of zinc oxide nanoparticles (ZnO-NPs) using Arthrospira platensis (Class: Cyanophyceae) and evaluation of their biomedical activities. Nanomaterials 2021, 11, 95. [Google Scholar] [CrossRef] [PubMed]
- Naseer, M.; Aslam, U.; Khalid, B.; Chen, B. Green route to synthesize Zinc Oxide Nanoparticles using leaf extracts of Cassia fistula and Melia azadarach and their antibacterial potential. Sci. Rep. 2020, 10, 9055. [Google Scholar] [CrossRef]
- Kacar, S.; Sahinturk, V. The Protective Agents Used against Acrylamide Toxicity: An In Vitro Cell Culture Study-Based Review. Cell J. (Yakhteh) 2021, 23, 367. [Google Scholar]
- Aref, M.S.; Salem, S.S. Bio-callus synthesis of silver nanoparticles, characterization, and antibacterial activities via Cinnamomum camphora callus culture. Biocatal. Agric. Biotechnol. 2020, 27, 101689. [Google Scholar] [CrossRef]
- Shaheen, T.I.; Salem, S.S.; Zaghloul, S. A new facile strategy for multifunctional textiles development through in situ deposition of SiO2/TiO2 nanosols hybrid. Ind. Eng. Chem. Res. 2019, 58, 20203–20212. [Google Scholar] [CrossRef]
- Abdel-Azeem, A.; Nada, A.A.; O’donovan, A.; Thakur, V.K.; Elkelish, A. Mycogenic silver nanoparticles from endophytic Trichoderma atroviride with antimicrobial activity. J. Renew. Mater. 2020, 8, 171. [Google Scholar] [CrossRef]
- Makarov, V.; Love, A.; Sinitsyna, O.; Makarova, S.; Yaminsky, I.; Taliansky, M.; Kalinina, N. “Green” nanotechnologies: Synthesis of metal nanoparticles using plants. Acta Nat. (англoязычная версия) 2014, 6, 35–44. [Google Scholar] [CrossRef]
- Biswal, B.; Kimberly, F.M.; Dwaye, D.; Anand, Y. Antimicrobial activity of leaf extracts of Guava (Psidium guajava) on two Gram positive and two Gram negative bacteria. Int. J. Microbiol. 2013, 2. [Google Scholar] [CrossRef]
- Arya, V. Living Systems: Eco-friendly nanofactories. Dig. J. Nanomater. Biostructures (DJNB) 2010, 5, 9–21. [Google Scholar]
- Mohamed, A.A.; Abu-Elghait, M.; Ahmed, N.E.; Salem, S.S. Eco-friendly mycogenic synthesis of ZnO and CuO nanoparticles for in vitro antibacterial, antibiofilm, and antifungal applications. Biol. Trace Elem. Res. 2021, 199, 2788–2799. [Google Scholar] [CrossRef]
- Salem, S.S.; El-Belely, E.F.; Niedbała, G.; Alnoman, M.M.; Hassan, S.E.-D.; Eid, A.M.; Shaheen, T.I.; Elkelish, A.; Fouda, A. Bactericidal and in-vitro cytotoxic efficacy of silver nanoparticles (Ag-NPs) fabricated by endophytic actinomycetes and their use as coating for the textile fabrics. Nanomaterials 2020, 10, 2082. [Google Scholar] [CrossRef] [PubMed]
- Fan, Z.; Lu, J.G. Zinc oxide nanostructures: Synthesis and properties. J. Nanosci. Nanotechnol. 2005, 5, 1561–1573. [Google Scholar] [CrossRef]
- Sushma, N.J.; Mahitha, B.; Mallikarjuna, K.; Raju, B.D.P. Bio-inspired ZnO nanoparticles from Ocimum tenuiflorum and their in vitro antioxidant activity. Appl. Phys. A 2016, 122, 544. [Google Scholar] [CrossRef]
- Hemavani, C.; Thippeswamy, B. Evaluation of antimicrobial property of Spirogyra species. Int. Multidiscip. Res. J. 2012, 2, 13–15. [Google Scholar]
- Peerapornpisal, Y. Edible freshwater macroalgae in Northern Thailand. Fish. Sci. J. 2007, 1, 178–188. [Google Scholar]
- Sharif, M.S.; Hameed, H.; Waheed, A.; Tariq, M.; Afreen, A.; Kamal, A.; Mahmoud, E.A.; Elansary, H.O.; Saqib, S.; Zaman, W. Biofabrication of Fe3O4 Nanoparticles from Spirogyra hyalina and Ajuga bracteosa and Their Antibacterial Applications. Molecules 2023, 28, 3403. [Google Scholar] [CrossRef]
- Younas, M.; Ahmad, M.A.; Jannat, F.T.; Ashfaq, T.; Ahmad, A. Role of silver nanoparticles in multifunctional drug delivery. In Nanomedicine Manufacturing and Applications; Elsevier: Amsterdam, The Netherlands, 2021; pp. 297–319. [Google Scholar]
- Azizi, S.; Ahmad, M.B.; Namvar, F.; Mohamad, R. Green biosynthesis and characterization of zinc oxide nanoparticles using brown marine macroalga Sargassum muticum aqueous extract. Mater. Lett. 2014, 116, 275–277. [Google Scholar] [CrossRef]
- Abboud, Y.; Saffaj, T.; Chagraoui, A.; El Bouari, A.; Brouzi, K.; Tanane, O.; Ihssane, B. Biosynthesis, characterization and antimicrobial activity of copper oxide nanoparticles (CONPs) produced using brown alga extract (Bifurcaria bifurcata). Appl. Nanosci. 2014, 4, 571–576. [Google Scholar] [CrossRef]
- Mahdavi, M.; Namvar, F.; Ahmad, M.B.; Mohamad, R. Green biosynthesis and characterization of magnetic iron oxide (Fe3O4) nanoparticles using seaweed (Sargassum muticum) aqueous extract. Molecules 2013, 18, 5954–5964. [Google Scholar] [CrossRef]
- Talam, S.; Karumuri, S.R.; Gunnam, N. Synthesis, characterization, and spectroscopic properties of ZnO nanoparticles. Int. Sch. Res. Not. 2012, 2012, 372505. [Google Scholar] [CrossRef]
- Srinivasan, N.; Rangasami, C.; Kannan, J. Synthesis structure and optical properties of zinc oxide nanoparticles. Int. J. Appl. Eng. Res. 2015, 10, 343–345. [Google Scholar]
- Fakhari, S.; Jamzad, M.; Kabiri Fard, H. Green synthesis of zinc oxide nanoparticles: A comparison. Green Chem. Lett. Rev. 2019, 12, 19–24. [Google Scholar] [CrossRef]
- Chaudhuri, S.K.; Malodia, L. Biosynthesis of zinc oxide nanoparticles using leaf extract of Calotropis gigantea: Characterization and its evaluation on tree seedling growth in nursery stage. Appl. Nanosci. 2017, 7, 501–512. [Google Scholar] [CrossRef]
- Irshad, S.; Salamat, A.; Anjum, A.A.; Sana, S.; Saleem, R.S.; Naheed, A.; Iqbal, A. Green tea leaves mediated ZnO nanoparticles and its antimicrobial activity. Cogent Chem. 2018, 4, 1469207. [Google Scholar] [CrossRef]
- Jayachandran, A.; Aswathy, T.; Nair, A.S. Green synthesis and characterization of zinc oxide nanoparticles using Cayratia pedata leaf extract. Biochem. Biophys. Rep. 2021, 26, 100995. [Google Scholar] [CrossRef]
- Sharmila, G.; Muthukumaran, C.; Sandiya, K.; Santhiya, S.; Pradeep, R.S.; Kumar, N.M.; Suriyanarayanan, N.; Thirumarimurugan, M. Biosynthesis, characterization, and antibacterial activity of zinc oxide nanoparticles derived from Bauhinia tomentosa leaf extract. J. Nanostructure Chem. 2018, 8, 293–299. [Google Scholar] [CrossRef]
- Anitha, R.; Ramesh, K.; Ravishankar, T.; Kumar, K.S.; Ramakrishnappa, T. Cytotoxicity, antibacterial and antifungal activities of ZnO nanoparticles prepared by the Artocarpus gomezianus fruit mediated facile green combustion method. J. Sci. Adv. Mater. Devices 2018, 3, 440–451. [Google Scholar] [CrossRef]
- Alamdari, S.; Sasani Ghamsari, M.; Lee, C.; Han, W.; Park, H.-H.; Tafreshi, M.J.; Afarideh, H.; Ara, M.H.M. Preparation and characterization of zinc oxide nanoparticles using leaf extract of Sambucus ebulus. Appl. Sci. 2020, 10, 3620. [Google Scholar] [CrossRef]
- Vidya, C.; Hiremath, S.; Chandraprabha, M.; Antonyraj, M.; Gopal, I.V.; Jain, A.; Bansal, K. Green synthesis of ZnO nanoparticles by Calotropis Gigantea. Int. J. Curr. Eng. Technol. 2013, 1, 118–120. [Google Scholar]
- Kołodziejczak-Radzimska, A.; Markiewicz, E.; Jesionowski, T. Structural characterisation of ZnO particles obtained by the emulsion precipitation method. J. Nanomater. 2012, 2012, 15. [Google Scholar] [CrossRef]
- Matinise, N.; Fuku, X.; Kaviyarasu, K.; Mayedwa, N.; Maaza, M. ZnO nanoparticles via Moringa oleifera green synthesis: Physical properties & mechanism of formation. Appl. Surf. Sci. 2017, 406, 339–347. [Google Scholar]
- Yathisha, R.; Nayaka, Y.A.; Vidyasagar, C. Microwave combustion synthesis of hexagonal prism shaped ZnO nanoparticles and effect of Cr on structural, optical and electrical properties of ZnO nanoparticles. Mater. Chem. Phys. 2016, 181, 167–175. [Google Scholar] [CrossRef]
- Dallatu, Y.; Shallangwa, G.; Africa, S. Synthesis and growth of spherical ZnO nanoparticles using different amount of plant extract. J. Appl. Sci. Environ. Manag. 2020, 24, 2147–2151. [Google Scholar] [CrossRef]
- Dobrucka, R.; Długaszewska, J. Biosynthesis and antibacterial activity of ZnO nanoparticles using Trifolium pratense flower extract. Saudi J. Biol. Sci. 2016, 23, 517–523. [Google Scholar] [CrossRef] [PubMed]
- Elavarasan, N.; Kokila, K.; Inbasekar, G.; Sujatha, V. Evaluation of photocatalytic activity, antibacterial and cytotoxic effects of green synthesized ZnO nanoparticles by Sechium edule leaf extract. Res. Chem. Intermed. 2017, 43, 3361–3376. [Google Scholar] [CrossRef]
- Nagarajan, S.; Arumugam Kuppusamy, K. Extracellular synthesis of zinc oxide nanoparticle using seaweeds of gulf of Mannar, India. J. Nanobiotechnology 2013, 11, 39. [Google Scholar] [CrossRef]
- Demissie, M.G.; Sabir, F.K.; Edossa, G.D.; Gonfa, B.A. Synthesis of zinc oxide nanoparticles using leaf extract of lippia adoensis (koseret) and evaluation of its antibacterial activity. J. Chem. 2020, 2020, 7459042. [Google Scholar] [CrossRef]
- Nagajyothi, P.; Cha, S.J.; Yang, I.J.; Sreekanth, T.; Kim, K.J.; Shin, H.M. Antioxidant and anti-inflammatory activities of zinc oxide nanoparticles synthesized using Polygala tenuifolia root extract. J. Photochem. Photobiol. B Biol. 2015, 146, 10–17. [Google Scholar] [CrossRef]
- Ahmed, J.; Ali, M.; Sheikh, H.M.; Al-Kattan, M.O.; Haroon, U.; Safaeishakib, M.; Akbar, M.; Kamal, A.; Zubair, M.S.; Munis, M.F.H. Biocontrol of Fruit Rot of Litchi chinensis Using Zinc Oxide Nanoparticles Synthesized in Azadirachta indica. Micromachines 2022, 13, 1461. [Google Scholar] [CrossRef]
- Kamal, A.; Haroon, U.; Manghwar, H.; Alamer, K.H.; Alsudays, I.M.; Althobaiti, A.T.; Iqbal, A.; Akbar, M.; Anar, M.; Nazish, M. Biological Applications of Ball-Milled Synthesized Biochar-Zinc Oxide Nanocomposite Using Zea mays L. Molecules 2022, 27, 5333. [Google Scholar] [CrossRef] [PubMed]
- Bennett, H.D. Algae of the Western Great Lakes Area; WC Brown Co. Publisher: Dubuque, IA, USA, 1951. [Google Scholar]

Disclaimer/Publisher’s Note: The statements, opinions and data contained in all publications are solely those of the individual author(s) and contributor(s) and not of MDPI and/or the editor(s). MDPI and/or the editor(s) disclaim responsibility for any injury to people or property resulting from any ideas, methods, instructions or products referred to in the content. |
© 2023 by the authors. Licensee MDPI, Basel, Switzerland. This article is an open access article distributed under the terms and conditions of the Creative Commons Attribution (CC BY) license (https://creativecommons.org/licenses/by/4.0/).
Share and Cite
Hameed, H.; Waheed, A.; Sharif, M.S.; Saleem, M.; Afreen, A.; Tariq, M.; Kamal, A.; Al-onazi, W.A.; Al Farraj, D.A.; Ahmad, S.; et al. Green Synthesis of Zinc Oxide (ZnO) Nanoparticles from Green Algae and Their Assessment in Various Biological Applications. Micromachines 2023, 14, 928. https://doi.org/10.3390/mi14050928
Hameed H, Waheed A, Sharif MS, Saleem M, Afreen A, Tariq M, Kamal A, Al-onazi WA, Al Farraj DA, Ahmad S, et al. Green Synthesis of Zinc Oxide (ZnO) Nanoparticles from Green Algae and Their Assessment in Various Biological Applications. Micromachines. 2023; 14(5):928. https://doi.org/10.3390/mi14050928
Chicago/Turabian StyleHameed, Hajra, Abdul Waheed, Muhammad Shakeeb Sharif, Muhammad Saleem, Afshan Afreen, Muhammad Tariq, Asif Kamal, Wedad A. Al-onazi, Dunia A. Al Farraj, Shabir Ahmad, and et al. 2023. "Green Synthesis of Zinc Oxide (ZnO) Nanoparticles from Green Algae and Their Assessment in Various Biological Applications" Micromachines 14, no. 5: 928. https://doi.org/10.3390/mi14050928
APA StyleHameed, H., Waheed, A., Sharif, M. S., Saleem, M., Afreen, A., Tariq, M., Kamal, A., Al-onazi, W. A., Al Farraj, D. A., Ahmad, S., & Mahmoud, R. M. (2023). Green Synthesis of Zinc Oxide (ZnO) Nanoparticles from Green Algae and Their Assessment in Various Biological Applications. Micromachines, 14(5), 928. https://doi.org/10.3390/mi14050928

